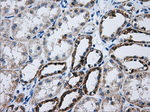
ATP5B Antibody in Immunohistochemistry (Paraffin) (IHC (P))

Search
OriGene
ATP5B Monoclonal Antibody (OTI6B11), TrueMAB™
{{$productOrderCtrl.translations['antibody.pdp.commerceCard.promotion.promotions']}}
{{$productOrderCtrl.translations['antibody.pdp.commerceCard.promotion.viewpromo']}}
{{$productOrderCtrl.translations['antibody.pdp.commerceCard.promotion.promocode']}}: {{promo.promoCode}} {{promo.promoTitle}} {{promo.promoDescription}}. {{$productOrderCtrl.translations['antibody.pdp.commerceCard.promotion.learnmore']}}
产品信息
TA500850
种属反应
宿主/亚型
分类
类型
克隆号
抗原
偶联物
形式
浓度
纯化类型
保存液
内含物
保存条件
运输条件
靶标信息
ATP synthase is extremely conserved through evolution and can be found in plants, fungi, bacteria, and animals. The ATP synthase enzyme is a transmembrane protein responsible for driving the reversible reaction from ADP+ phosphate to ATP. This reaction is accomplished by a flux of protons across the membrane as a result of electron transfer. The ATP synthase protein has two main sections; the F1 ATP-ase (soluble) and the F0 ATP-ase (membrane embedded). The F1 section consists of the alpha, beta, gamma, delta, and epsilon subunits. While the F0 consists of a, b, and c subunits.
仅用于科研。不用于诊断过程。未经明确授权不得转售。
篇参考文献 (0)
生物信息学
蛋白别名: ATP synthase F1 subunit beta; ATP synthase subunit beta, mitochondrial; epididymis secretory protein Li 271; MGC5231; mitochondrial ATP synthase beta subunit; mitochondrial ATP synthetase, beta subunit
基因别名: ATP5B; ATP5F1B; ATPMB; ATPSB; HEL-S-271
UniProt ID: (Human) P06576
Entrez Gene ID: (Human) 506